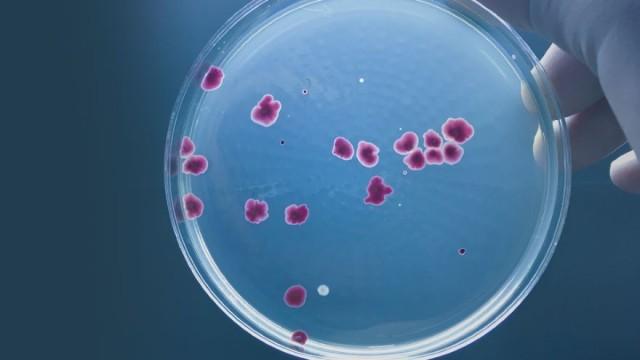
Microbiomes: Evolution with Small Partners

What Darwin Didn't Know: The Modern Science of Evolution
1 season • 2018 • Ended
Documentary
Chart the deep insights and remarkable conclusions Charles Darwin’s ideas on natural selection inspired. These 24 fascinating episodes cover 160 years of non-stop scientific advances and their relationship to Darwin’s groundbreaking theory. Among them: the discovery of the rules of heredity, the identification of DNA, the recognition of mass extinctions, and the power to manipulate genes.
Chart the deep insights and remarkable conclusions Charles Darwin’s ideas on natural selection inspired. These 24 fascinating episodes cover 160 years of non-stop scientific advances and their relationship to Darwin’s groundbreaking theory. Among them: the discovery of the rules of heredity, the identification of DNA, the recognition of mass extinctions, and the power to manipulate genes.
Episodes
Loading comments...